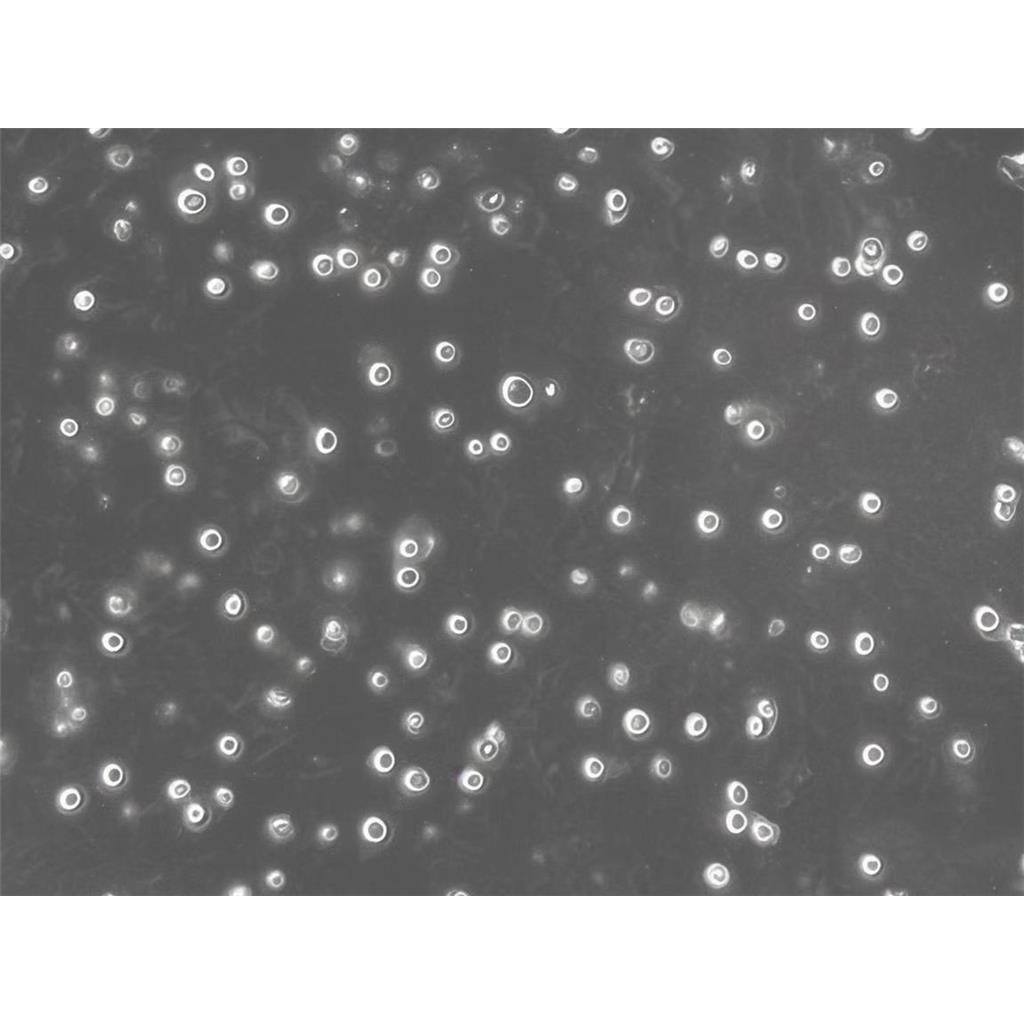
MARC-145 Cells非洲绿猴胚胎肾细胞批次新|送STR图谱

"MARC-145 Cells非洲绿猴胚胎肾细胞批次新|送STR图谱
细胞别名:Marc-145; MARC 145; Marc 145; MARC145; Marc145; Meat Animal Research Center-145
传代比例:1:2-1:4(首次传代建议1:2)
生长特性:贴壁生长
换液周期:每周2-3次
U-251 Cells;背景说明:U-251 MG分离至一位患者的胶质母细胞瘤组织。;传代方法:1:2-1:3传代;每周换液2-3次。;生长特性:贴壁;形态特性:成纤维细胞样;相关产品有:Hs 606细胞、293E细胞、CT26-clone 25细胞
Leukemic 1210 Cells;背景说明:该细胞源于用0.2%甲基胆蒽(溶解)涂抹雌性小鼠的皮肤诱发的肿瘤,鼠痘病毒阴性。;传代方法:1:2传代;生长特性:悬浮生长;形态特性:淋巴母细胞样;相关产品有:NCI-H2108细胞、H-1693细胞、Co320细胞
DMS-53 Cells;背景说明:详见相关文献介绍;传代方法:1:2-1:3传代,每周2-3次;生长特性:贴壁生长;形态特性:上皮样;相关产品有:HPDEC细胞、Hs 695.T细胞、HL-7702细胞
活细胞:通常具有透亮的外观、完整的细胞膜,以及清晰可见的细胞核和细胞质内的细胞器。对于贴壁细胞,活细胞能够牢固地贴附在培养皿或培养瓶上。死细胞:则呈现暗淡无光、细胞膜可能碎裂的状态,且无法有效贴壁(对于贴壁细胞而言)。悬浮细胞死细胞则可能表现出膜碎裂、内容物外泄等现象。不同类型的细胞具有特定的生长形态,如成纤维型细胞呈细长形状并附着在基质上生长,上皮型细胞呈多边形等。观察细胞是否保持其特有的生长形态也是判断细胞状态的重要依据。细胞培养员应及时记录细胞培养过程中的关键数据,包括细胞形态、染色结果、生长速度等。建立完善的数据记录系统,有助于追踪细胞状态的变化,并为后续分析提供依据。
MARC-145 Cells非洲绿猴胚胎肾细胞批次新|送STR图谱
┈订┈购(技术服务)┈热┈线:1┈3┈6┈4┈1┈9┈3┈0┈7┈9┈1【微信同号】┈Q┈Q:3┈1┈8┈0┈8┈0┈7┈3┈2┈4;
背景信息:胚肾;自发永生
产品包装:复苏发货:T25培养瓶(一瓶)或冻存发货:1ml冻存管(两支)
贴壁细胞的传代培养,详细步骤如下:首先倒掉培养基,在这一步骤可以收集一些细胞上清做支原体检测;加入胰蛋白酶,一般T25是加2mL,盖好瓶盖,摇晃T25培养瓶,使胰蛋白酶均匀覆盖在细胞表面,放入培养箱2-3min,期间可在显微镜下观察,看到大部分细胞变圆,即可放入超净台,加入2倍的完全培养基,这里就是加4mL培养基,终止消化;将含有胰蛋白酶,细胞和培养基一起转移到离心管中,1000rpm/3min离心,去掉上清;新鲜的完全培养基重悬,根据细胞的生长特性和后续的实验需求进行传代,比如我养的Hepa1-6就长的比较快,不是着急用的话,我就会按1E6个细胞/T75培养瓶进行传代;但如果后两天要用,就会适当多传一点;还可通过显微镜计数后,直接用于细胞铺板,继续后续的实验。
来源说明:细胞主要来源ATCC、ECACC、DSMZ、RIKEN等细胞库
物种来源:人源、鼠源等其它物种来源
MARC-145 Cells非洲绿猴胚胎肾细胞批次新|送STR图谱
┈订┈购(技术服务)┈热┈线:1┈3┈6┈4┈1┈9┈3┈0┈7┈9┈1【微信同号】┈Q┈Q:3┈1┈8┈0┈8┈0┈7┈3┈2┈4;
GP5d Cells;背景说明:结肠癌;女性;传代方法:1:2-1:3传代;每周换液2-3次。;生长特性:贴壁;形态特性:详见产品说明书;相关产品有:SKES-1细胞、OCI-AML2细胞、Vero细胞
BMF Cells;背景说明:详见相关文献介绍;传代方法:1:2-1:4传代;生长特性:贴壁生长;形态特性:详见产品说明书;相关产品有:TK10细胞、SW 1990细胞、N9细胞
T2(174 x CEM.T2) Cells;背景说明:详见相关文献介绍;传代方法:1:3—1:6传代,每周换液2—3次;生长特性:悬浮生长;形态特性:淋巴母细胞样;相关产品有:PANC.1细胞、H295R细胞、CNE2Z细胞
HCT/Taxo1 Cells;背景说明:详见相关文献介绍;传代方法:1:2-1:3传代;每周换液2-3次。;生长特性:贴壁或悬浮,详见产品说明书部分;形态特性:详见产品说明书;相关产品有:NTERA2-D1细胞、RKN细胞、NW-MEL-38细胞
形态特性:上皮细胞样
购买的细胞死亡或细胞存活率不佳可能原因?研究人员在细胞培养时出现存活率不佳,原因比较复杂,常见原因可归纳为:培养基使用错误或培养基品质不佳;血清使用错误或血清的品质不佳;解冻过程错误;冷冻细胞解冻后,加以洗涤细胞和离心;悬浑细胞误认为死细胞;培养温度使用错误;细胞置于-80℃太久等。建议严格参照AC的标准操作规程进行细胞复苏、冻存等工作。欲将一般动物细胞离心下来,其离心速率应为多少转速?欲回收动物细胞,其离心速率一般为300×g(约1OOOrpm),5-10分钟,转速过GAO或离心时间过长都将造成细胞死亡。合适的离心转速是根据相对离心力决定。RCF=1.119×105×r×(rpm)2,其中r为离心机转轴中心与离心套管底部内壁的距离;rpm为离心机每分钟的转数;RCF(relaive nrifugal for)为相对离心力,以重力加速度g(980.66cm/s2)的倍数来表示单位。
CCK81 Cells;背景说明:详见相关文献介绍;传代方法:1:2-1:3传代;每周换液2-3次。;生长特性:贴壁或悬浮,详见产品说明书部分;形态特性:详见产品说明书;相关产品有:HLE-B3细胞、IOSE29细胞、NCI H23细胞
INS-1 Cells;背景说明:该细胞源自X射线照射的移植胰岛瘤的大鼠,胰岛素阳性,可合成胰岛素原I和II,可用于beta细胞功能研究。;传代方法:1:3—1:6传代,每周换液2—3次;生长特性:贴壁生长;形态特性:不规则,多角;相关产品有:BALL1细胞、22Rv1细胞、COLO 206细胞
U 266 Cells;背景说明:详见相关文献介绍;传代方法:1:3传代,2-3天传一代;生长特性:悬浮生长 ;形态特性:淋巴母细胞样;相关产品有:SUDHL-4细胞、AML-EOL-1细胞、HCS-2/8细胞
hA549 Cells;背景说明:详见相关文献介绍;传代方法:1:2-1:3传代;每周换液2-3次。;生长特性:贴壁或悬浮,详见产品说明书部分;形态特性:详见产品说明书;相关产品有:MOLT16细胞、OVCA420细胞、Hs863T细胞
OV1/P Cells;背景说明:详见相关文献介绍;传代方法:1:2-1:3传代;每周换液2-3次。;生长特性:贴壁或悬浮,详见产品说明书部分;形态特性:详见产品说明书;相关产品有:CA46细胞、MDAMB435细胞、CCD18细胞
HPDE Cells;背景说明:详见相关文献介绍;传代方法:1:2传代;生长特性:贴壁生长 ;形态特性:详见产品说明书;相关产品有:PC2细胞、CTSC-3细胞、P3X63 AG 8.653细胞
CV1 Cells;背景说明:CV-1细胞株是1964年由JensenFC等建系的,源自成年雄性非洲绿猴肾,被用于Rous肉瘤病毒的转染研究。可作为SV40载体的转染宿主。;传代方法:1:2传代;生长特性:贴壁生长;形态特性:成纤维细胞样;相关产品有:OVISE细胞、HSC细胞、H-2110细胞
GM05384 Cells;背景说明:详见相关文献介绍;传代方法:1:2-1:3传代;每周换液2-3次。;生长特性:贴壁或悬浮,详见产品说明书部分;形态特性:详见产品说明书;相关产品有:RWPE1细胞、MCF10-A细胞、SW403细胞
OVCAR 4 Cells;背景说明:详见相关文献介绍;传代方法:1:2-1:3传代;每周换液2-3次。;生长特性:贴壁或悬浮,详见产品说明书部分;形态特性:详见产品说明书;相关产品有:TSCC1细胞、HIEC细胞、NPA-87细胞
MESSA Dx5 Cells;背景说明:详见相关文献介绍;传代方法:1:2-1:8传代;每周2-3次。;生长特性:贴壁生长;形态特性:成纤维细胞样 ;相关产品有:PASMCS细胞、CCD19-Lu细胞、U251细胞
SNU878 Cells;背景说明:详见相关文献介绍;传代方法:1:2传代;生长特性:贴壁或悬浮,详见产品说明书部分;形态特性:详见产品说明书;相关产品有:L cell细胞、CMECs细胞、A-875细胞
AMO1 Cells;背景说明:浆细胞骨髓瘤;女性;传代方法:1:2-1:3传代;每周换液2-3次。;生长特性:半贴壁;形态特性:详见产品说明书;相关产品有:RKO-AS-45-1细胞、MHCC 97-L细胞、OPM2细胞
HBL-1 [Human diffuse large B-cell lymphoma] Cells;背景说明:弥漫大B淋巴瘤;男性;传代方法:1:2-1:3传代;每周换液2-3次。;生长特性:悬浮;形态特性:详见产品说明书;相关产品有:RPMI8402细胞、NIH3T3细胞、C 643细胞
MFM223 Cells;背景说明:详见相关文献介绍;传代方法:1:2-1:3传代;每周换液2-3次。;生长特性:贴壁或悬浮,详见产品说明书部分;形态特性:详见产品说明书;相关产品有:TMD8细胞、Hepatoma 22细胞、P3J-HR-1细胞
COLO829 Cells;背景说明:详见相关文献介绍;传代方法:1:3-1:6传代,2-3天换液1次。;生长特性:贴壁生长;形态特性:成纤维细胞;相关产品有:HS-695T细胞、L-02细胞、H341细胞
Hs706T Cells;背景说明:详见相关文献介绍;传代方法:1:2—1:3传代;每周换液2-3次;生长特性:贴壁生长;形态特性:成纤维细胞;相关产品有:SR786细胞、JC细胞、Panc02细胞
AC29 Cells;背景说明:详见相关文献介绍;传代方法:1:2-1:3传代;每周换液2-3次。;生长特性:贴壁或悬浮,详见产品说明书部分;形态特性:详见产品说明书;相关产品有:HEC-1-B细胞、H8细胞、GM3190细胞
26586 Cells(提供STR鉴定图谱)
Abcam HeLa RABAC1 KO Cells(提供STR鉴定图谱)
AG24369 Cells(提供STR鉴定图谱)
BayGenomics ES cell line RRI068 Cells(提供STR鉴定图谱)
BayGenomics ES cell line XH527 Cells(提供STR鉴定图谱)
C2024 Cells(提供STR鉴定图谱)
┈订┈购(技术服务)┈热┈线:1┈3┈6┈4┈1┈9┈3┈0┈7┈9┈1【微信同号】┈Q┈Q:3┈1┈8┈0┈8┈0┈7┈3┈2┈4;
DA00016 Cells(提供STR鉴定图谱)
DA04743 Cells(提供STR鉴定图谱)
FRIMOi006-A Cells(提供STR鉴定图谱)
THP-1(ATCC) Cells;背景说明:该细胞从一名1岁的患有急性单核细胞性白血病的男孩的外周血中分离建立。该细胞可以吞噬乳胶颗粒和激活的红细胞,细胞膜和胞浆内均没有免疫球蛋白,表达C3R和FcR;可受佛波酯TPA诱导向单核系方向分化;可作为转染宿主。;传代方法:维持细胞浓度在2-4×105-8×105/ml,勿超过1×106/ml;2-3天换液1次。;生长特性:悬浮生长;形态特性:单核细胞;相关产品有:J.E6-1细胞、BLO-11细胞、Vero 76细胞
NCI-H1993 Cells;背景说明:详见相关文献介绍;传代方法:1:2—1:6传代;生长特性:贴壁或悬浮,详见产品说明书部分;形态特性:详见产品说明书;相关产品有:PTK 1细胞、HuH-6细胞、P3/NS1/Ag4-1细胞
OSC19 Cells;背景说明:舌鳞癌;男性;传代方法:1:2-1:3传代;每周换液2-3次。;生长特性:贴壁;形态特性:详见产品说明书;相关产品有:BL-6细胞、SEG-1细胞、SU86_86细胞
SKMES Cells;背景说明:源于一位65岁患有肺鳞状细胞癌的白人男性,自转移性胸腔积液分离而来。;传代方法:1:2传代;生长特性:贴壁生长;形态特性:上皮样;相关产品有:THLE2细胞、HcerEpic细胞、hFOB1.19细胞
MARC-145 Cells非洲绿猴胚胎肾细胞批次新|送STR图谱
EO771 Cells;背景说明:恶性乳腺癌;雌性;C57BL/6;传代方法:1:2-1:3传代;每周换液2-3次。;生长特性:贴壁;形态特性:详见产品说明书;相关产品有:NCIH841细胞、BALB/3T3 cl. A31细胞、Hs 852.T细胞
H1238 Cells;背景说明:详见相关文献介绍;传代方法:1:2-1:3传代;每周换液2-3次。;生长特性:贴壁或悬浮,详见产品说明书部分;形态特性:详见产品说明书;相关产品有:Dysplastic Oral Keratinocyte细胞、PC-3M-IE8细胞、A549-Taxol细胞
MC38 Cells;背景说明:详见相关文献介绍;传代方法:1:2传代;生长特性:贴壁生长;形态特性:上皮细胞样;相关产品有:QG56细胞、H-1238细胞、OCM1A细胞
mIMCD-3 Cells;背景说明:肾;内髓集合管;上皮 Cells;传代方法:1:2-1:3传代;每周换液2-3次。;生长特性:贴壁;形态特性:详见产品说明书;相关产品有:NIH:OVCAR4细胞、BJA-B细胞、H1882细胞
SNU-387 Cells;背景说明:详见相关文献介绍;传代方法:1:2传代;生长特性:贴壁生长;形态特性:上皮样;相关产品有:H-1395细胞、NCIH1105细胞、UMNSAH/DF#1细胞
U031 Cells;背景说明:详见相关文献介绍;传代方法:1:3-1:6传代;2-3天换液1次。;生长特性:贴壁生长;形态特性:上皮样;相关产品有:HEL299细胞、NCIH1385细胞、CCF-STTG1细胞
G401 Cells;背景说明:详见相关文献介绍;传代方法:1:2-1:6传代,每周2-3次。;生长特性:贴壁生长;形态特性:上皮细胞样;相关产品有:PaTu-8988s细胞、GM03571细胞、H322细胞
MonoMac 6 Cells;背景说明:详见相关文献介绍;传代方法:1:2传代;生长特性:悬浮生长;形态特性:淋巴母细胞;相关产品有:MDA-MB-231-luc细胞、LA795细胞、AMC-HN-8细胞
MD Anderson-Metastatic Breast-157 Cells;背景说明:该细胞源自一位患有乳腺髓样癌的44岁黑人女性,表达WNT7B癌基因,细胞与细胞边界处有细胞桥粒、微绒毛、张力细丝。;传代方法:1:2-1:3传代;每周换液2-3次。;生长特性:贴壁生长;形态特性:上皮样;相关产品有:MDCKII细胞、NCI-HUT-596细胞、SK-ES细胞
114-50D4 Cells(提供STR鉴定图谱)
SK-MEL-3 Cells;背景说明:详见相关文献介绍;传代方法:1:3-1:5传代,2-3天换液1次。;生长特性:贴壁生长;形态特性:成纤维细胞;相关产品有:HBZY-1细胞、GM07404D细胞、Strain L-929细胞
HAP1 ADCY6 (-) 1 Cells(提供STR鉴定图谱)
HAP1 SGK223 (-) 2 Cells(提供STR鉴定图谱)
HCC-95 Cells;背景说明:详见相关文献介绍;传代方法:1:2-1:3传代;每周换液2-3次。;生长特性:贴壁或悬浮,详见产品说明书部分;形态特性:详见产品说明书;相关产品有:Kit-225细胞、HDQ-P1细胞、DMS-273细胞
NCI-H345 Cells;背景说明:小细胞肺癌;骨髓转移;男性;传代方法:1:2-1:3传代;每周换液2-3次。;生长特性:贴壁;形态特性:详见产品说明书;相关产品有:MOVAS-1细胞、MAC1细胞、K-1735细胞
SCC15 Cells;背景说明:详见相关文献介绍;传代方法:1:4-1:8传代,2-3天换液1次。;生长特性:贴壁生长;形态特性:详见产品说明书;相关产品有:H1092细胞、NCI-H1694细胞、Colo699细胞
Tca-8113 Cells;背景说明:舌鳞癌;女性;传代方法:1:2-1:3传代;每周换液2-3次。;生长特性:贴壁;形态特性:详见产品说明书;相关产品有:KM12细胞、Hca-F细胞、NP-69细胞
OCI Ly10 Cells;背景说明:弥漫大B细胞淋巴瘤;传代方法:1:2-1:3传代;每周换液2-3次。;生长特性:悬浮;形态特性:详见产品说明书;相关产品有:SCL-1细胞、HD-LM-2细胞、A2780-CP细胞
H-1734 Cells;背景说明:详见相关文献介绍;传代方法:1:4-1:6传代。;生长特性:贴壁生长;形态特性:上皮细胞样;相关产品有:JM-1细胞、3T3NIH细胞、HBL-100细胞
P30-OHK Cells;背景说明:详见相关文献介绍;传代方法:10^5 cells/60mm dish;生长特性:悬浮生长;形态特性:淋巴母细胞;相关产品有:MDA468细胞、KU812-F细胞、H441细胞
MASMC Cells;背景说明:气道平滑肌;传代方法:1:2-1:3传代;每周换液2-3次。;生长特性:贴壁;形态特性:详见产品说明书;相关产品有:MDA-MB-468-RED细胞、K562/ADR细胞、RPMI8226细胞
HyCyte INS-1 KO-rSsr1 Cells(提供STR鉴定图谱)
LCL Orang Asli K37 Cells(提供STR鉴定图谱)
N1E-115-1 Cells(提供STR鉴定图谱)
OVC.ID.22 Cells(提供STR鉴定图谱)
RT 1 Cells(提供STR鉴定图谱)
ts-655 Cells(提供STR鉴定图谱)
UKTS9020 Cells(提供STR鉴定图谱)
HAP1 TNFRSF12A (-) 2 Cells(提供STR鉴定图谱)
ABE8.1/2 Cells;背景说明:淋巴瘤;BALB/c;传代方法:1:2-1:3传代;每周换液2-3次。;生长特性:悬浮;形态特性:详见产品说明书;相关产品有:Bovine ENDometrial cells细胞、RC-K8细胞、FL 62891细胞
C 643 Cells;背景说明:甲状腺未分化癌;男性;传代方法:1:2-1:3传代;每周换液2-3次。;生长特性:贴壁;形态特性:详见产品说明书;相关产品有:NPC-TW 01细胞、HTh74细胞、MDA-453细胞
SKN-SH Cells;背景说明:SK-N-SH细胞系由J.L.Bieder建系,它与SK-N-MC所不同的是倍增时间较长且多巴胺-β-羟基酶水平较高。 SK-N-SH在细胞介导的细胞毒性试验中用作靶细胞系。;传代方法:1:2传代;生长特性:悬浮生长;形态特性:上皮细胞样;相关产品有:Hs606细胞、GOS-3细胞、B16-F0细胞
HCV-29 Cells;背景说明:膀胱;男性;传代方法:1:2-1:3传代;每周换液2-3次。;生长特性:贴壁;形态特性:详见产品说明书;相关产品有:E.L.4细胞、NCI-H-295细胞、Hmy.2 CIR细胞
Hca-F Cells;背景说明:肝癌;传代方法:1:2-1:3传代;每周换液2-3次。;生长特性:贴壁;形态特性:详见产品说明书;相关产品有:ARO81细胞、RASMCs细胞、SK Mel 2细胞
Hca-F Cells;背景说明:肝癌;传代方法:1:2-1:3传代;每周换液2-3次。;生长特性:贴壁;形态特性:详见产品说明书;相关产品有:ARO81细胞、RASMCs细胞、SK Mel 2细胞
VMRCRCZ Cells;背景说明:详见相关文献介绍;传代方法:1:6传代;生长特性:贴壁生长;形态特性:上皮细胞;相关产品有:BE(2)-C细胞、SL1细胞、NU-GC-3细胞
SKG-IIIa Cells;背景说明:详见相关文献介绍;传代方法:2x10^4 cells/ml;生长特性:贴壁生长;形态特性:上皮细胞样;相关产品有:IOSE80细胞、BC-019细胞、H-2196细胞
HBZY 1 Cells;背景说明:详见相关文献介绍;传代方法:1:2传代;生长特性:贴壁生长;形态特性:上皮细胞样;相关产品有:HOS-MNNG细胞、HEK-293F细胞、REC1细胞
A-549 Cells;背景说明:详见相关文献介绍;传代方法:1:2-1:3传代;每周换液2-3次。;生长特性:贴壁或悬浮,详见产品说明书部分;形态特性:详见产品说明书;相关产品有:MDAMB468细胞、HCC1937细胞、P30-OHK细胞
HARA-B Cells;背景说明:详见相关文献介绍;传代方法:1:2-1:3传代;每周换液2-3次。;生长特性:贴壁或悬浮,详见产品说明书部分;形态特性:详见产品说明书;相关产品有:HUCCT1细胞、MARC145细胞、DR2R1610细胞
HBZY 1 Cells;背景说明:详见相关文献介绍;传代方法:1:2传代;生长特性:贴壁生长;形态特性:上皮细胞样;相关产品有:HOS-MNNG细胞、HEK-293F细胞、REC1细胞
RA Cells;背景说明:详见相关文献介绍;传代方法:1:2-1:3传代;每周换液2-3次。;生长特性:贴壁或悬浮,详见产品说明书部分;形态特性:详见产品说明书;相关产品有:T47D细胞、NCIH2291细胞、MV522细胞
TJ905 Cells;背景说明:胶质瘤;传代方法:1:2-1:3传代;每周换液2-3次。;生长特性:贴壁;形态特性:详见产品说明书;相关产品有:CCC-HEL-1细胞、SNU-407细胞、Pa017C细胞
D283-MED Cells;背景说明:详见相关文献介绍;传代方法:每周换液2-3次。;生长特性:悬浮细胞的多细胞聚集体,和一些贴壁 Cells;形态特性:上皮细胞;相关产品有:MBVP细胞、CAL 78细胞、WM115-mel细胞
teno-iPSC3 Cells(提供STR鉴定图谱)
MBT-2 Cells;背景说明:膀胱移行细胞癌;C3H/He;传代方法:1:2-1:3传代;每周换液2-3次。;生长特性:贴壁;形态特性:详见产品说明书;相关产品有:HEY-A8细胞、HT-1376细胞、EC109细胞
NCI-N87 Cells;背景说明:NCI-N87细胞表达表面糖蛋白癌胚抗原(CEA)和TAG72,并且没有左旋多巴胺脱羧酶(DDC)活性。它们的血管活性的肠肽(VIP)受体活性极低并缺乏胃泌激素受体。它们表达蕈毒碱胆碱受体。没有证据表明存在N-myc,L-myc,myb和EGF受体基因的重组。这个细胞株表达的c-myc和c-erb-B2RNA水平与其它细胞株相当。以下基因不表达:N-myc,L-myc,c-cis,IGF-2,或胃泌激素释放肽。报道NCI-N87细胞的植板率为4.3%。;传代方法:消化15-20分钟。1:2。4-5天长满。;生长特性:贴壁生长;形态特性:上皮细胞样;相关产品有:NRK细胞、NCI-H2196细胞、Fetal Bovine Heart Endothelial细胞
H-1618 Cells;背景说明:详见相关文献介绍;传代方法:3-4天换液1次。;生长特性:悬浮生长;形态特性:详见产品说明书;相关产品有:PCI:SG-231细胞、JROECL 33细胞、BC-019细胞
MALME 3M Cells;背景说明:详见相关文献介绍;传代方法:1:2-1:4传代,2天换液1次。;生长特性:混合生长;形态特性:成纤维细胞;相关产品有:A204细胞、HaCaT细胞、MDCK II细胞
MEG-01 Cells;背景说明:MEG-01细胞株源自一位CML患者成巨核细胞转换期的骨髓细胞。细胞质因子VIII和表面球蛋白IIb/IIIa,-Schiff(PAS)反应,α醋酸酯酶和酸性酶阳性。髓过氧化物酶,α酯酶,化醋酸AS-D酯酶和碱性酶阴性。用单克隆抗体BA-1(抗B细胞,粒性白细胞),HPL-3(抗球蛋白IIb/IIIa)和20.3(抗单核细胞,血小板)染色成阳性。其他淋巴和骨髓类抗体成阴性。;传代方法:1:2传代。3天内可长满。;生长特性:悬浮生长;形态特性:淋巴母细胞样;相关产品有:NCI-H165细胞、CAL 33细胞、LOU-NH91细胞
Panc_08_13 Cells;背景说明:详见相关文献介绍;传代方法:1:2传代;生长特性:贴壁生长;形态特性:上皮样;相关产品有:CCD-112CoN细胞、Jurkat 77细胞、PCI-4M细胞
SW-1116 Cells;背景说明:CSAp阴性(CSAp-)。 结肠抗原3,阴性。 角蛋白免疫过氧化物酶染色阳性。 癌基因c-myc, K-ras, H-ras, myb, sis 和fos的表达呈阳性。 未检测到癌基因N-myc和N-ras的表达。 表达肿瘤特异的核基质蛋白CC-4,CC-5和CC-6。;传代方法:消化3-5分钟。1:2。3天内可长满。;生长特性:贴壁生长;形态特性:上皮细胞;相关产品有:CL1细胞、Transformed Human Liver Epithelial-3细胞、MODE-K细胞
OE-21 Cells;背景说明:详见相关文献介绍;传代方法:1:2传代;生长特性:贴壁生长;形态特性:上皮样;相关产品有:Colon26细胞、Jurkat E6.1细胞、H250细胞
CTLL-2 Cells;背景说明:该细胞是源自C57BL/6的细胞毒性的T淋巴细胞。其生长以来IL-2。;传代方法:1:2传代;生长特性:悬浮生长;形态特性:详见产品说明书;相关产品有:M14细胞、CemT4细胞、KLM-1细胞
McA-RH 8994 Cells;背景说明:详见相关文献介绍;传代方法:1:2-1:3传代;每周换液2-3次。;生长特性:贴壁或悬浮,详见产品说明书部分;形态特性:详见产品说明书;相关产品有:A-375细胞、MKN1细胞、Vero细胞
┈订┈购(技术服务)┈热┈线:1┈3┈6┈4┈1┈9┈3┈0┈7┈9┈1【微信同号】┈Q┈Q:3┈1┈8┈0┈8┈0┈7┈3┈2┈4;
HCC-1187 Cells;背景说明:详见相关文献介绍;传代方法:1:2传代,每周换液2—3次;生长特性:混合生长;形态特性:上皮样;相关产品有:High 5细胞、Jiyoye(P-2003)细胞、TOV-21G细胞
Hep 3B Cells;背景说明:肝癌;男性;传代方法:1:2-1:3传代;每周换液2-3次。;生长特性:贴壁;形态特性:详见产品说明书;相关产品有:Factor Dependent Continuous-Paterson 1细胞、NT2D1细胞、HDLM2细胞
CCRF/CEM Cells;背景说明:G.E. Foley 等人建立了类淋巴母细胞细胞株CCRF-CEM。 细胞是1964年11月从一位四岁白人女性急性淋巴细胞白血病患者的外周血白血球衣中得到。此细胞系从香港收集而来。;传代方法:1:2传代。3天内可长满。;生长特性:悬浮生长;形态特性:淋巴母细胞样;相关产品有:Hs343T细胞、NCI-H1355细胞、MDA-MB-231-luc细胞
HTh-74 Cells;背景说明:未分化甲状腺癌;女性;传代方法:1:2-1:3传代;每周换液2-3次。;生长特性:贴壁;形态特性:详见产品说明书;相关产品有:HFT-8810细胞、SNU-1040细胞、FDCP1细胞
MARC-145 Cells非洲绿猴胚胎肾细胞批次新|送STR图谱
BayGenomics ES cell line RRA017 Cells(提供STR鉴定图谱)
BayGenomics ES cell line XE077 Cells(提供STR鉴定图谱)
CPTC-XMRV P12-3 Cells(提供STR鉴定图谱)
MEM-E/02 Cells(提供STR鉴定图谱)
SMA-540 Cells(提供STR鉴定图谱)
LoVo_6244R Cells(提供STR鉴定图谱)
"